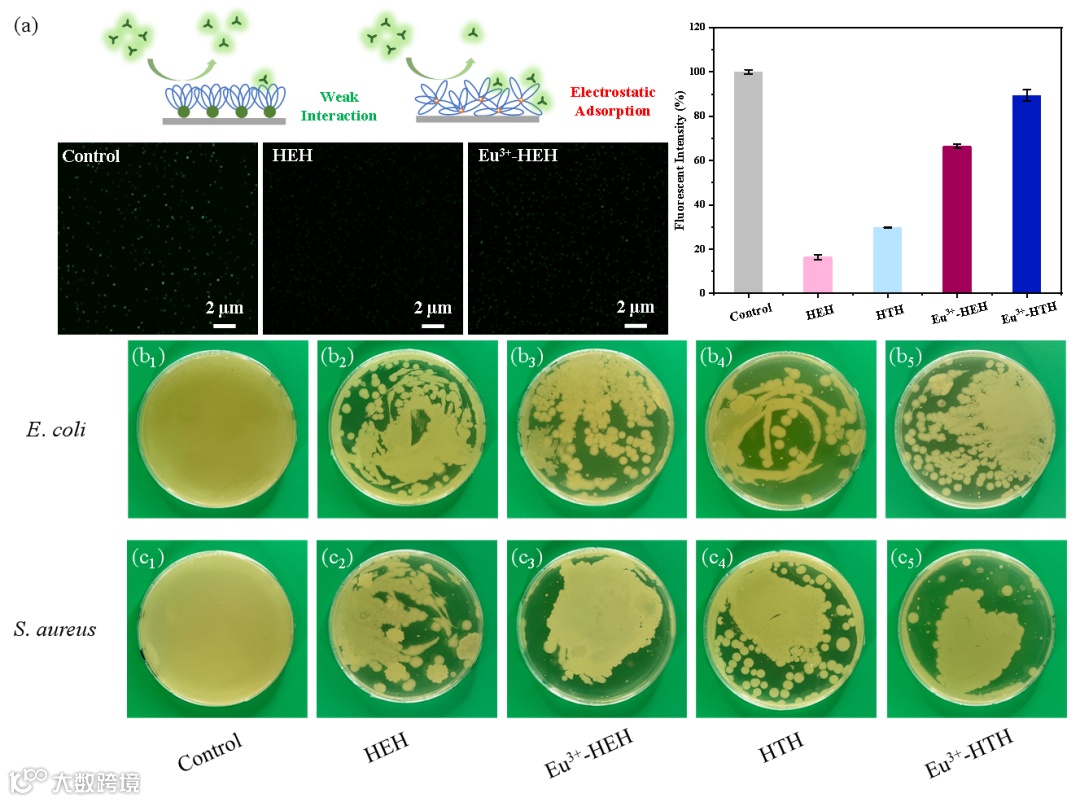

AIE荧光分子近年来是生物材料领域的一大研究热点,然而受到聚合物微观形态的影响,AIE高分子的聚集诱导发光性能往往与典型的AIE分子不尽相同。目前,仍没有系统的研究解释某类AIE高分子的荧光性能与其聚集状态之间的关系。因此,通过研究建立以上关系是实现聚合物荧光调控的一大挑战,并有望对精细化生物成像与下一代生物材料的制备提供新的解决思路。

图1吡啶二甲酸官能化聚醚及其铕配合物的自组装结构与生物性能
近来,北京化工大学材料科学与工程学院程红波教授团队通过简单的化学合成制备了一类吡啶二甲酸(DPA)末端官能化聚醚高分子及其铕配合物(图1),通过对官能化聚合物的自组装行为与聚集态结构的深入研究,结合其荧光性能表现,归纳总结出适用于此类高分子的特殊自组装诱导AIE行为。同时,得益于这类聚合物优异的水溶性与DPA优异的配位性能,可以成功合成水溶性荧光铕(Eu3+)配位聚合物,解决Eu3+配合物在水溶液中荧光淬灭难题。利用DPA与Eu3+配合物优异的抗菌活性,可以实现具有抗菌性能新型荧光生物材料的制备。该工作以“Facile Assembly Strategy for Luminescent Lanthanide Nanoparticles with Antibacterial Activity Using Aggregation-Inducing Emission Polymers”为题发表在《Macromolecules》上。文章第一作者是北京化工大学硕士研究生文簙锌。文章通讯作者是北京化工大学程红波教授,该研究得到国家自然科学基金委的支持。

图2 (a)HTH不同浓度梯度的紫外吸收及其 (b) 在352 nm处的规律拟合;(c) HTH在不同H2O/EtOH配比溶剂中的荧光发射情况及其 (d) 在309、327和378 nm处的发射强度规律
作者首先制备了DPA末端官能化的聚乙二醇(HEH)与聚四氢呋喃(HTH),并表征了其具体的化学结构与纳米结构。为了确定其荧光性能与聚集态结构之间的内在关联,作者对两类聚合物不同梯度浓度的紫外光谱与不同优劣溶剂配比溶液的荧光发射光谱进行了表征测试(图2),结果发现其紫外最大吸收与荧光峰值随聚合物聚集态变化并不符合传统AIE分子的增长规律。有意思的是,作者注意到该峰值变化规律可以被Boltzmann函数很好地拟合,呈现出一种特异性AIE变化趋势。

图3 HEH溶于 (a) H2O, (b) H2O/EtOH (vol : vol = 2:1), (c) H2O/EtOH (vol : vol = 1:2) 和 (d) EtOH后在硅片上滴膜并在60 °C退火2 h的SEM图像;HEH 的H2O 溶液在(e) 硅片边界, (f) 液滴外缘, (g) 液滴边缘 (h) 液滴中心的SEM图像;(i) 上述微观组装体在硅片中的分布状况

图4 (a) HEH在H2O, H2O/EtOH (fv=90%)与HTH在EtOH,EtOH/H2O (fv=90%)中的T2谱对比;随着劣溶剂体积分数fv(poor solvent)变化(b) HEH与 (d) HTH的归一化T2谱瀑布图以及 (c) HEH与 (e) HTH关于fv(poor solvent)和T2 之间的Boltzmann 拟合曲线; (f) HEH 与HTH在不同极性溶液中的缺陷聚集机理与导致其产生的竞争性抑制动力学过程的宏观-微观示意图
为阐述这种特异性AIE效应产生的原因,本文作者先对聚合物不同的聚集状态进行了深入探究。作者结合前文描述的多级自组装机理,采用SEM表征了HEH在不同极性溶剂中经过相同组装时间形成纳米组装体与在同种良溶剂中经过不同组装时间形成的纳米组装体的形貌完整性(图3),证实了在聚合物自组装过程中“缺陷”的存在。为了进一步量化“缺陷”与“完美组装”的状态,作者采用低场核磁(LF-NMR)对不同极性溶剂中自组装聚合物的横向弛豫时间(T2)进行测试,通过组装体的活性氢弛豫性能表征组装体的“平均缺陷程度”,最终发现这一过程也可以被Boltzmann 函数很好地拟合。基于以上结果,作者提出了缺陷聚集机理,即在这类AIE聚合物中其完美组装体可以实现经典AIE效应变化规律,但组装缺陷会同时存在并与完美组装体发生竞争性抑制,最终导致产生Boltzmann转变过程。

图5 (a) 空白样,HEH与Eu3+-HEH membranes抗BSA蛋白粘附性的CLSM测试图像对比与相关的荧光强度统计图以及样品抗蛋白机理示意;空白样, HEH, Eu3+-HEH, HTH 和 Eu3+-HTH 采用平板涂布法针对 (b1-b5) E. coli 和 (c1-c5) S. aureus的抗菌测试
作者指出,在络合Eu3+后,聚合物能够发射显著的红色荧光,且其在水溶液中未发生荧光淬灭,经荧光光谱分析配位还可以通过天线效应增强中心离子的荧光。这种材料具有显著的抗蛋白性能与良好的抗菌性能,有望制备一种新型的荧光生物涂层并运用于生物医用领域。
原文链接:
https://pubs.acs.org/doi/10.1021/acs.macromol.2c02445
相关进展
复旦朱亮亮课题组通过光激发实现有机相AIE并可视化指导聚合物材料的溶液加工和自组装
新加坡国立大学刘斌教授课题组AM:具有AIE的生物正交配位聚合物纳米颗粒用于肿瘤深度穿透的放疗和放动力治疗
北京化工大学顾星桂教授、杨万泰院士和香港科技大学唐本忠院士合作:基于AIE效应的自稳定沉淀聚合机理的荧光可视化揭示及生物医学应用
苏州大学路建美教授课题组系统评述:AIE功能聚合物的制备、性能及应用

高分子科技原创文章。欢迎个人转发和分享,刊物或媒体如需转载,请联系邮箱:info@polymer.cn

欢迎专家学者提供稿件(论文、项目介绍、新技术、学术交流、单位新闻、参会信息、招聘招生等)至info@polymer.cn,并请注明详细联系信息。高分子科技®会及时推送,并同时发布在中国聚合物网上。
欢迎加入微信群 为满足高分子产学研各界同仁的要求,陆续开通了包括高分子专家学者群在内的几十个专项交流群,也包括高分子产业技术、企业家、博士、研究生、媒体期刊会展协会等群,全覆盖高分子产业或领域。目前汇聚了国内外高校科研院所及企业研发中心的上万名顶尖的专家学者、技术人员及企业家。
申请入群,请先加审核微信号PolymerChina(或长按下方二维码),并请一定注明:高分子+姓名+单位+职称(或学位)+领域(或行业),否则不予受理,资格经过审核后入相关专业群。